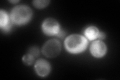
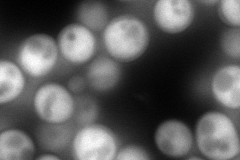
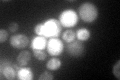

View description
Nitric oxide oxidoreductase, flavohemoglobin involved in nitric oxide detoxification; plays a role in the oxidative and nitrosative stress responses
Localization:
Intensity:
Fold change:
Significance:
-
C’ GFP library in SD
cytosol246.7 -
N' NOP1pr-GFP in SD
cytosol247.658 -
N' TEF2pr-mCherry in SD

cell periphery,vacuole0 -
N' NATIVEpr-GFP in SD

cytosol137.747 -
N' TEF2pr-VC and Cyto-VN in SD

#N/A0 -
C’ GFP library in SD+DTT

cytosol43.190.17Yes -
C’ GFP library in SD+H2O2

cytosol263.211.06No -
C’ GFP library in Starvation Media
cytosol131.240.53Yes -
C’ GFP library on the background of Pup2-DaMP

N/A -
C’ GFP library on the background of CCT mutant

N/A0N/AYes
